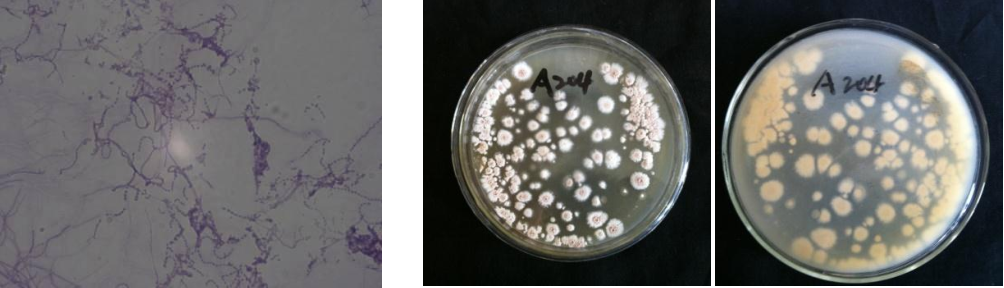

Loading...
| StrainNO | A204 |
| Classification | Streptomyces |
| 16s rDNA sequence | |
| Strain Morphology Photos | |
| Morphological Description | hyphae:branched;separated without breaking;filament:long;curled;Spore pile:white clam meat;barrel-shaped or nearly round |